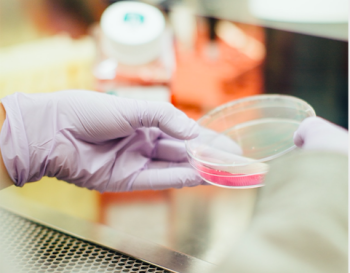

STIRI . ARTICOLE . Divertisment
În fiecare an, sezonul de Crăciun schimbă complet consumul de muzică la nivel global. YouTube devine principala platformă unde publicul…
[VOQ] 21/12/2025
Amenzi uriaşe pentru cei care folosesc petarde sau pocnitori în noaptea de Revelion
În timp ce poliţiştii confiscă zeci de mii de petarde şi...
[Observator] 30/12/2025
[Observator] 30/12/2025
Parlamentul unei țări din UE a interzis petardele și artificiile. Care este motivul
Mâine va fi ultima noapte de Revelion în care locuitorii Olandei vor...
[Gândul] 30/12/2025
[Gândul] 30/12/2025
Un studiu dezvăluie modalitatea prin care melanomul „păcăleşte” celulele sistemului imunitar
O echipă internaţională de oameni de ştiinţă a descoperit o...
[Ecopolitic] 30/12/2025
[Ecopolitic] 30/12/2025
PROTEVELION dă startul noului an cu energie, muzică, dans și un premiu de 10.000 de euro
În noaptea de 31 decembrie, începând cu ora 20:00, unii dintre cei...
[InfoMusic] 30/12/2025
[InfoMusic] 30/12/2025
Mai mulți artiști protestează față de o ordonanță a Guvernului Bolojan. Tudor Chirilă, Irina Rimes și Loredana Groza, printre semnatari
Peste 300 de artiști, autori și profesioniști din industria...
[HotNews] 30/12/2025
[HotNews] 30/12/2025
Condiții speciale de pensionare pentru anumiți români, din 2026. Cine sunt persoanele vizate de noile măsuri
Țara noastră intră într-o nouă etapă a reformei pensiilor,...
[Gândul] 30/12/2025
[Gândul] 30/12/2025
Revelion 2026 în Piața Alba Iulia: Spectacole multimedia și concerte live. Acessul este gratuit
Bucureștenii sunt invitați în noaptea de Revelion să întâmpine...
[B1 Tv] 30/12/2025
[B1 Tv] 30/12/2025
Cristi Borcea, ofertat să participe la concursul TV! Milionarul l-a văzut pe Prunea și nu s-a ferit de cuvinte
Fostul conducător al lui Dinamo București, Cristi Borcea, a...
[ProSport] 30/12/2025
[ProSport] 30/12/2025
La Arad, tradiția artificiilor de Revelion se păstrează. Primarul municipiului: Problemele cele mai mari nu sunt focurile de artificii, ci de faptul că în decembrie și ianuarie „lumea aruncă...
Contrar deciziei unor municipalități, care au renunțat la...
[Europa FM] 30/12/2025
[Europa FM] 30/12/2025
Cea mai grea perioadă prin care a trecut Narcisa Suciu. ”M-am prins de chiuvetă și am crezut că o s-o smulg din perete”
Cântăreața Narcisa Suciu, în vârstă de 50 de ani, și-a amintit...
[Gândul] 30/12/2025
[Gândul] 30/12/2025
Top 10 orașe din Europa perfecte pentru a sărbători Revelionul 2026
Aceste destinații se remarcă drept cele mai bune opțiuni pentru a...
[Gândul] 30/12/2025
[Gândul] 30/12/2025
Prefigurări ale anului 2026
Orice exprimare are un punct de plecare. Într-un moment în...
[Amos News] 30/12/2025
[Amos News] 30/12/2025
Brigitte Bardot: 20 de fapte care explică o viață trăită între glorie, retragere și controversă
Brigitte Bardot, actrița franceză care a devenit un simbol al...
[Descopera] 30/12/2025
[Descopera] 30/12/2025
Obiceiuri și tradiții în Ajun de Anul Nou. Cele mai frumoase datini pe care românii le practică și astăzi
PlugușorulÎn satele din mai multe zone ale țării, în dimineața...
[Realitatea] 30/12/2025
[Realitatea] 30/12/2025
Justin Bieber rupe tăcerea: „Am crescut într-o industrie care recompensa talentul meu, dar nu mi-a protejat mereu sufletul”
Justin Bieber a făcut un apel emoționant pentru ca industria...
[Ştirile ProTv] 30/12/2025
[Ştirile ProTv] 30/12/2025
Alexia Ţalavutis şi Pepe dau startul Bătăliei pe veselie, pe 31 decembrie, de la ora 16.00, la Antena 1 şi pe AntenaPLAY
În ultima zi din an, începând cu ora 16.00, o nouă ediție...
[SpyNews] 30/12/2025
[SpyNews] 30/12/2025
Revelion 2026 în Piața Alba Iulia – spectacol multimedia și concerte live, cu acces gratuit
Primăria Sectorului 3 invită bucureștenii să întâmpine...
[Amos News] 30/12/2025
[Amos News] 30/12/2025
MESAJE DE ANUL NOU 2026. Idei de SMS-uri, urări şi felicitări pe care le puteţi trimite celor dragi de Revelion
MESAJE DE ANUL NOU 2026. Idei de SMS-uri, urări şi felicitări pe...
[Unirea] 30/12/2025
[Unirea] 30/12/2025
Alexia Ţalavutis şi Pepe dau startul Bătăliei pe veselie, pe 31 decembrie, de la ora 16.00
În ultima zi din an, începând cu ora 16.00, o nouă ediție...
[Observator] 30/12/2025
[Observator] 30/12/2025
Un milion de vizitatori, la West Side Christmas Market! Târgul de Crăciun din Parcul Drumul Taberei și-a închis porțile aseară
S-a încheiat încă un capitol din povestea West Side Christmas...
[Amos News] 30/12/2025
[Amos News] 30/12/2025
Beyoncé a devenit miliardară și a treia cel mai bine plătită muziciană din lume
Beyoncé a atins oficial statutul de multimilionară după un an...
[Gazeta de Sud] 30/12/2025
[Gazeta de Sud] 30/12/2025
Zodiac. Cel mai fidel partener. Bărbații născuți în aceste luni sunt considerați cei mai buni soți
Alegerea unui soț implică mai mult decât atracție și...
[Gândul] 30/12/2025
[Gândul] 30/12/2025
(VIDEO) Programul Inspire Mercur Craiova între 2 – 8 ianuarie
Primate / Instinct primar Avanpremiera
Regia: Johannes Roberts
...
[Gazeta de Sud] 30/12/2025
[Gazeta de Sud] 30/12/2025
Șoldan anunță că azi s-a scos la licitație centura orașului Gura Humorului: „Este o veste extraordinară pentru întreaga noastră istorie ca județ”
Președintele Consiliului Județean Suceava, Gheorghe Șoldan, a...
[Suceava News] 30/12/2025
[Suceava News] 30/12/2025
Revelion 2026 în Piața Alba Iulia – singurul Revelion în aer liber din București, cu spectacole multimedia și concerte live, acces gratuit
Revelionul din Sectorul 3 va culmina, la miezul nopții, cu un...
[Realitatea] 30/12/2025
[Realitatea] 30/12/2025
Ștefan Bănică urcă alături de Emilia Popescu pe scenă, la Revelionul cel mai neBUN. Numărul plin de umor va fi văzut pe Antena 1 și AntenaPLAY în noaptea dintre ani
Numere de dans, momente umoristice, cei mai renumiți artiști din...
[SpyNews] 30/12/2025
[SpyNews] 30/12/2025
Coregrafa Simona Deaconescu este mereu în mișcare: „Trăim într-o perioadă în care și arta este într-o zonă mai activistă”
La finalul lunii august 2025, am luat parte la repetiția deschisă a...
[ELLE] 30/12/2025
[ELLE] 30/12/2025
Bărbat internat forțat la Spitalul de Psihiatrie și pentru Măsuri de Siguranță Pădureni în baza unei hotărâri judecătorești definitive
La data de 29 decembrie orele 14:00, lucrătorii Secției 10 Poliție...
[Suceava News] 30/12/2025
[Suceava News] 30/12/2025
ZIARE . REVISTE
Divertisment
TEME DIVERSE
-
Animale
Anunţuri
Artă & Cultură
Auto-moto
Bucatarie
Cinema
Copii şi părinţi
Diaspora
Divertisment
Educatie
Femei & fete
Finanţe Afaceri
Foto
Imobiliare
Informatica
Jocuri video
Meteo
Mondene
Muzica
Politica, Istorie
Profesionale
Publicitate
Radio
Sanatate
Satira & Umor
Spiritualitate
Stiinţă, Tehnică
Turism Natură
| Adăugarea sau scoaterea conținutului dvs | Contact
|
ZIAR.COM : știri libere | știri tv live și știri de ultima oră
Ziar.com indexează publicații diverse, ziare și reviste cu poziții diferite, existente independent online. Ideile și comentariile exprimate în aceste articole nu reflectează opiniile Ziar.com și nu pot fi imputate acestuia. Pentru orice informație complementară sau reclamație cu privire la conținut, consultați direct ziarele relevante – sursa este întotdeauna indicată, cu un link spre articolul de origină.
Publicare, realizare si gazduire web : DIRECTWAY. Toate drepturile rezervate, reproducerea interzisa - Copyright © 1996-2025 DIRECTWAY